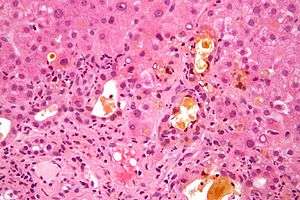

Elevated alkaline phosphatase
| Elevated alkaline phosphatase | |
|---|---|
![]() | |
| Micrograph showing changes that may be associated with an elevated alkaline phosphatase (cholestasis and feathery degeneration). Liver biopsy. H&E stain. | |
| Classification and external resources | |
| Specialty | Pathology |
| ICD-10 | R74.8 |
| ICD-9-CM | 790.5 |
Elevated alkaline phosphatase describes the situation where the levels of alkaline phosphatase (ALP) exceed the reference range. This group of enzymes has a low substrate specificity and catalyzes the hydrolysis of phosphate esters in an acidic environment. The major function of alkaline phosphatase is transporting across cell membranes.[1] Alkaline phosphatases are present in many human tissues, including bone, intestine, kidney, liver, placenta and white blood cells.[2] Damage to these tissues causes the release of ALP into the bloodstream. Elevated levels can be detected through a blood test. Elevated alkaline phosphate is associated with certain medical conditions[3] or syndromes (e.g., hyperphosphatasia with mental retardation syndrome, HPMRS). It serves as a significant indication for certain medical conditions, diseases and syndromes.
If the reason for alkaline phosphatase is unknown, isoenzyme studies using electrophoresis can confirm the source of the ALP. Heat stability also distinguishes bone and liver isoenzymes ("bone burns, liver lasts").
Liver
- Liver (liver ALP):
Bone/skeletal
- Bone disease (bone ALP):
- Paget's disease,[4] osteosarcoma, bone metastases of prostatic cancer (High / very high ALP values)
- Other bone metastases
- Renal osteodystrophy
- Fractured bone
- Multiple myeloma (only when associated with fractures)
- Skeletal involvement of other primary diseases:
- Osteomalacia, rickets, vitamin D deficiency (moderate rise)
- Malignant tumors (ALP originating from tumor)
- Renal disease (secondary hyperparathyroidism)
- Primary hypothyroidism
Other unlisted musculoskeletal conditions may also cause elevated alkaline phosphatase.
Obesity
Elevated levels of the alkaline phosphatase enzyme are reported with those who have obesity. A study reported there were higher serum levels of alkaline phosphatase in obese than in the non obese. With elevated alkaline phosphatase levels there is an increase in disproportionate intracellular fat depots and thereby releasing itself into the bloodstream. The relationship between alkaline phosphatase and obesity is still being tested.[5]
Kidney
Elevated serum levels of alkaline phosphatase has been associated with Chronic Kidney Disease (CKD). Recently, studies have shown that elevated levels may predict mortality independent of bone metabolism factors and liver function tests in CKD.[6] This distinction is indicated by the markers of inflammations specifically from C-reactive protein (CRP) with elevated levels of alkaline phosphatase. Hence, elevated serum alkaline phosphatase activity may be a marker for inflammation because of its association with elevated levels of CRP.
Cancer
Elevated alkaline phosphatase in patients with cancer normally spans throughout the bones or liver. Metastasize that exist in the lung, breast, prostate, colon, thyroid, and further organs can penetrate in the liver or bone.[8] Yet, cancers that are already present in certain organs and tissues can produce alkaline phosphatase elevations if metastasis is not present. Isoenzymes, which are certain forms of alkaline phosphatase generated by these tumors, enlarges the total volume of alkaline phosphatase levels on experiential studies. The Regan isoenzyme[9] is one of the best studies of these isoenzymes that is linked to several human cancers. Basically, the Regan isozenzyme is an alkaline phosphatase that is located in the placenta and associated with the gonadal and urologic cancers.
- Breast carcinoma
- Colon cancer
- Leukemia - cancer of the bone marrow
- Lymphoma
- Pancreatic cancer
- Lung cancer
- Hodgkin's lymphoma - cancer of the white blood cells
Testing
An alkaline phosphatase isoenzyme test can be done to check for elevated ALP levels. Tissues that contain high levels of ALP include the liver, bile ducts, and bones. Normal levels of ALP range from 44 to 147 U/L (units per liter) and significantly elevated levels may be an indication of conditions such as various types of cancer, bone disease such as Paget disease, liver disease such as hepatitis, blood disorders, or other conditions.[10]
Elevated alkaline phosphatase is most commonly caused by liver disease or bone disorders. Testing for ALP primarily consists of obtaining a blood sample from a patient along with several other tests for the disorder in question that may be associated with the increase in ALP in the blood serum.[11] It is possible to distinguish between the different forms (isoenzymes) of ALP produced by different types of tissues in the body, in order to pinpoint what's causing the increase of ALP, in order to treat the patient for either liver disease or bone disorder. A more rapid way for testing ALP concentration is by using p-nitrophenyl phosphate as substrate.[12] The required volume of serum is 5 cubic mm. for each testing. The sample is first incubated for 30 min. at 38 °C, in a buffered solution in the presence of p-nitrophenyl phosphate. By the action of ALP, phosphate groups are removed from the substrate and para- nitrophenol is liberated giving off a yellow color in solution which can be measured spectrophotometrically.[13]
Other
- Lung cancer
- Prostate cancer
- Chlorpropamide therapy
- Infectious mononucleosis
- Pancreatic carcinoma
- Primary sclerosing cholangitis
- Polycythemia vera
- Myelofibrosis
- Leukemoid reaction to infection
- Women using hormonal contraception
- Pregnancy
- Herpes zoster (shingles)
- Rickets - vitamin D deficiency
- Amyloidosis
- Granulation tissue
- Gastrointestinal inflammation - inflammatory bowel disease (ulcerative colitis, Crohn’s disease) or ulcers)
- Rheumatoid arthritis
- Ankylosing Spondylitis
- Transient hyperphosphatasaemia of infancy: benign, often associated with infection
- Seminoma[14]
- Hyperthyroidism[15]
- Celiac disease [16]
- Sarcoid[17]
- Syphilis[18]
Treatments
The following are the most common treatments of elevated alkaline phosphatase.[19]
- Treatment of the underlying condition
- Once doctors identifies the cause of elevated ALP and diagnose a treatment, the levels of alkaline phosphatase fluctuates back to normal
- Removal of medication - that is associated with increased levels of alkaline phosphatase
- Birth control pills
- Anti-inflammatory medication
- Narcotic medication
- Hormonal drug
- Steroid
- Antidepressant
- Dietary changes
- Include foods rich in vitamin D
- Lifestyle change
- Healthy diet in association with physical exercise
- Exposure to sunlight which increases the production of vitamin D
References
- ↑ Celik, Handan; Tosun, Midraci; Cetinkaya, Mehmet Bilge; Bektab, Ahmet; Malatyalýodlu, Erdal (2009-08-01). "Markedly elevated serum alkaline phosphatase level in an uncomplicated pregnancy". The Journal of Maternal-Fetal & Neonatal Medicine: The Official Journal of the European Association of Perinatal Medicine, the Federation of Asia and Oceania Perinatal Societies, the International Society of Perinatal Obstetricians. 22 (8): 705–707. doi:10.1080/14767050802702323. ISSN 1476-4954. PMID 19544151.
- ↑ Kaplan, Marshall M. "Alkaline Phosphatase". New England Journal of Medicine. 286 (4): 200–202. doi:10.1056/nejm197201272860407.
- ↑ Li-Fern H, Rajasoorya C (February 1999). "The elevated serum alkaline phosphatase--the chase that led to two endocrinopathies and one possible unifying diagnosis". Eur. J. Endocrinol. 140 (2): 143–7. doi:10.1530/eje.0.1400143. PMID 10069658.
- ↑ Gennari L, Di Stefano M, Merlotti D, et al. (October 2005). "Prevalence of Paget's disease of bone in Italy". J. Bone Miner. Res. 20 (10): 1845–50. doi:10.1359/JBMR.050518. PMID 16160742.
- ↑ Khan, Abdul Rehman; Awan, Fazli Rabbi; Najam, SyedaSadia; Islam, Mehboob; Siddique, Tehmina; Zain, Maryam (2015). "Elevated serum level of human alkaline phosphatase in obesity". Journal of Pakistan Medical Association. 65 (11): 1182–1185. Retrieved 2016-05-19.
- ↑ Damera, Sriharsha; Raphael, Kalani L.; Baird, Bradley C.; Cheung, Alfred K.; Greene, Tom; Beddhu, Srinivasan (2011-01-02). "Serum alkaline phosphatase levels associate with elevated serum C-reactive protein in chronic kidney disease". Kidney International. 79 (2): 228–233. doi:10.1038/ki.2010.356.
- ↑ Damera, Sriharsha (September 2010). "Serum alkaline phosphatase levels associate with elevated serum C-reactive protein in chronic kidney disease". International Society of Nephrology.
- ↑ Christensen, Stephen. "Elevated Alkaline Phosphatase & Cancer |". LIVESTRONG.COM. Retrieved 2016-05-10.
- ↑ Fishman, W. H. (1980-01-01). "Immunology and biochemistry of the Regan isoenzyme". The Prostate. 1 (4): 399–410. doi:10.1002/pros.2990010403. ISSN 0270-4137. PMID 7024957.
- ↑ "ALP - blood test". MedlinePlus. Retrieved 2016-05-10.
- ↑ Majeska, Robert (April 10, 1982). "The Effect of 1,25(OH)zD3 on Alkaline Phosphatase in Osteoblastic Osteosarcoma Cell". The Journal of Biological Chemistry.
- ↑ BESSEY, O. A.; LOWKY, O. H.; BROCK, M. J. (1946-01-01). "A method for the rapid determination of alkaline phosphatase with five cubic millimeters of serum.". Journal of Biological Chemistry. 164. ISSN 0021-9258.
- ↑ BESSEY, O. A.; LOWKY, O. H.; BROCK, M. J. (1946-01-01). "A method for the rapid determination of alkaline phosphatase with five cubic millimeters of serum.". Journal of Biological Chemistry. 164. ISSN 0021-9258.
- ↑ Lange PH, Millan JL, Stigbrand T, Vessella RL, Ruoslahti E, Fishman WH (August 1982). "Placental alkaline phosphatase as a tumor marker for seminoma". Cancer Res. 42 (8): 3244–7. PMID 7093962.
- ↑ L Tibi; A W Patrick; P Leslie; A D Toft; A F Smith (1989-07-01). "Alkaline phosphatase isoenzymes in plasma in hyperthyroidism". Clinchem.org. Retrieved 2014-07-03.
- ↑ Pruessner, Harold T, “Detecting Celiac Disease in your Patients” American Family Physician: 57 (5), March 1, 1998 pp1023-1034.
- ↑ Eur J Gastroenterol Hepatol. 2012 Jan;24(1):17-24. doi: 10.1097/MEG.0b013e32834c7b71. Liver-test abnormalities in sarcoidosis. Cremers J, Drent M, Driessen A, Nieman F, Wijnen P, Baughman R, Koek G.
- ↑ Pareek, S. S., “Liver involvement in secondary syphilis” Digestive Diseases and Sciences: 24 (1), January 1979 pp41-43.
- ↑ "Elevated Alkaline Phosphatase - Levels, Causes and Treatment". healthh.com. Retrieved 2016-05-19.
External links
- Alkaline phosphatase at Lab Tests Online